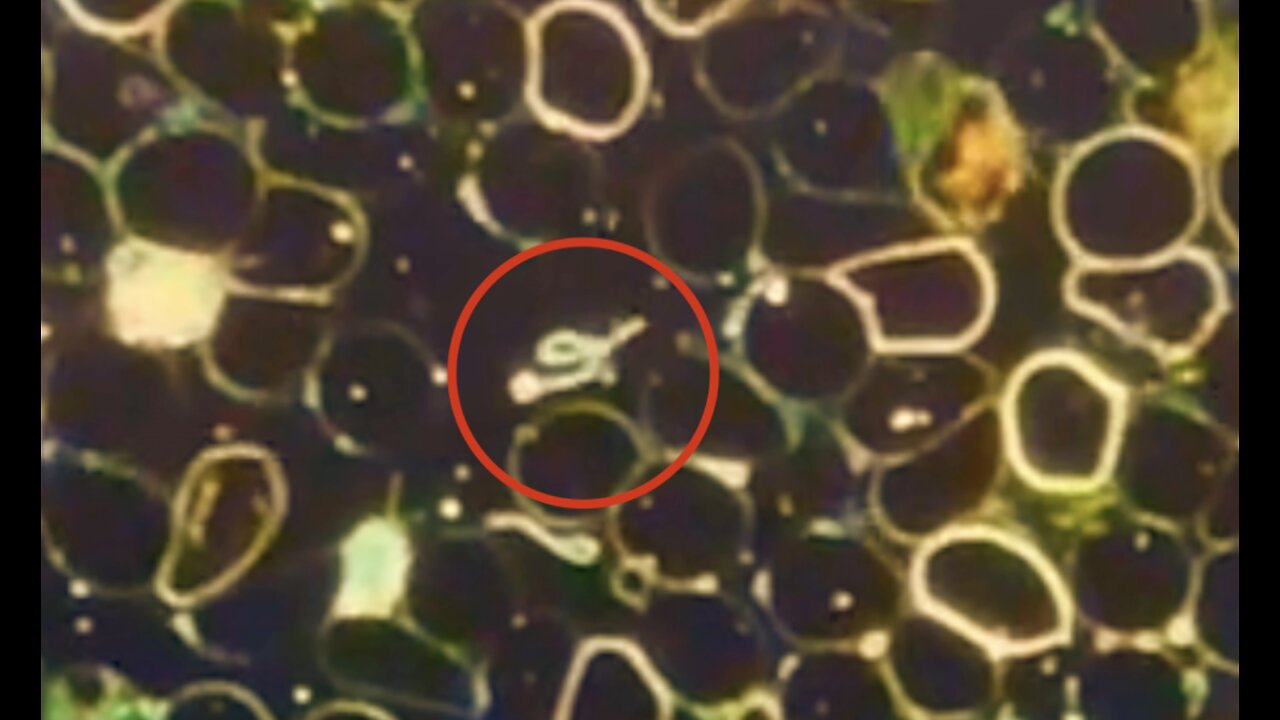
September 8, 2022

Premium Only Content
This video is only available to Rumble Premium subscribers. Subscribe to
enjoy exclusive content and ad-free viewing.
September 8, 2022
Loading comments...
-
 44:52
44:52
Donald Trump Jr.
5 hours agoShip Outta Luck, Plus FBI Foils LA Terror Plot and Much More | Triggered Ep.300
215K102 -
 12:50
12:50
Dr. Nick Zyrowski
4 days agoThe AMAZING Health Benefits of NAC ( N-Acetyl Cysteine) - Must See!
24.4K14 -
 1:15:43
1:15:43
We Like Shooting
14 hours ago $1.11 earnedDouble Tap 440 (Gun Podcast)
7.94K -
 59:03
59:03
BonginoReport
5 hours agoEvil Terrorists Target Jewish Celebration - Nightly Scroll w/ Hayley Caronia (Ep.197)
51.2K56 -
 1:02:27
1:02:27
The Nick DiPaolo Show Channel
7 hours agoRob Reiner, Wife Slaughtered | The Nick Di Paolo Show #1828
42.4K33 -
 22:03
22:03
Jasmin Laine
10 hours agoCBC Host Left SPEECHLESS as Poilievre Uses Their OWN Words Against Them
23.4K25 -
 13:09:53
13:09:53
LFA TV
1 day agoLIVE & BREAKING NEWS! | MONDAY 12/15/25
214K53 -
 1:18:27
1:18:27
Kim Iversen
5 hours agoShould Muslims Be Allowed in the West? | Candace and Erika Kirk FACE OFF
100K236 -
 1:59:22
1:59:22
The Mike Schwartz Show
10 hours agoTHE MIKE SCHWARTZ SHOW Evening Edition 12-15-2025
20K3 -
 1:48:12
1:48:12
Redacted News
6 hours agoHIGH ALERT! BONDI BEACH FALSE FLAG ATTACK AS POLICE STOOD DOWN FOR 20 MINUTES, STRATEGY OF TENSION!
187K170